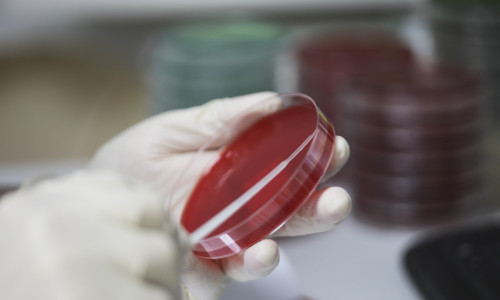
coronavirus ID133805_INQUAM_Photos_Octav_Ganea

Internările pentru operații și investigații care nu sunt urgente se suspendă pentru 14 zile
Toate internările pentru operații și investigații care nu sunt urgente se suspendă pentru 14 zile în toată țara. De asemenea, în 48 de ore vor fi externați toți pacienții care nu reprezintă urgențe, potrivit unui comunicat al Grupului de Comunicare Strategică.